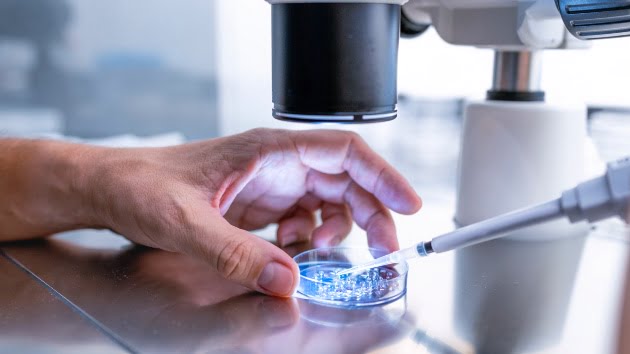

(LOS ANGELES) — Two couples have filed lawsuits against in vitro fertilization provider Ovation Fertility alleging its clinic destroyed their embryos when a lab employee wrongly used hydrogen peroxide instead of a sterile solution in an incubator.
The couples allege that the clinic still used the embryos despite knowing they were nonviable. Neither woman got pregnant.
In two nearly identical lawsuits filed on Thursday against Ovation Fertility in Newport Beach, California, two unnamed couples are asserting multiple claims, including negligent misrepresentation, fraud, negligence and medical battery. The couples are not revealing their names in the lawsuits to protect their privacy, according to the suits.
In two nearly identical lawsuits filed on Thursday, two unnamed couples are accusing Ovation Fertility in Newport Beach, California, of negligent misrepresentation fraud, negligence and medical battery. The couples are not revealing their names in the lawsuits to protect their privacy, according to the suits.
Embryos belonging to likely dozens of patients were destroyed by hydrogen peroxide in the latter half of January 2024, the couples’ attorney, Adam Wolf, said in a press conference Thursday.
The clinic did not realize there was a problem with the embryos until they saw low success rates for implantation in January and investigated why, Wolf told ABC News. Wolf said Ovation Fertility then reached out to at least some of the impacted patients.
Ovation Fertility did not immediately respond to ABC News’ request for comment regarding the suits.
The couples allege they may not be able to have children who are biologically related to them — since they say they have no more viable embryos — because of Ovation Fertility’s actions.
In the suits, the couples claim the hydrogen peroxide killed their embryos before they were transferred and that there was no chance they would become pregnant.
The suits, filed in California Superior Court, seek jury trials and are asking for an unspecified amount of damages.
The couples allege that the clinic put an extremely unsafe amount of hydrogen peroxide in an incubator used to store the embryos and failed to have the proper procedures and protocols in place to ensure the toxic incubator would not harm their embryos despite the clinic’s claims to the contrary.
“Hydrogen peroxide is something that can be in the lab of a fertility clinic; there is nothing wrong with that,” Wolf said. “What was entirely wrong about this was the levels and concentration of hydrogen peroxide that was used in this incubator apparently having mixed up hydrogen peroxide and a sterile solution,” Wolf said at the press conference.
“This was an error that had massive implications for likely dozens of patients,” Wolf said. “This killed their embryos. In certain states, those are human beings.”
They also allege that the clinic did not properly train their employees on how to operate, manage or maintain the embryo incubator.
The couples also allege they were told their embryos were viable and had not been harmed at the time of the transfer, despite allegedly knowing that this was not true.
One couple said they only had one genetically normal embryo and it was destroyed in the incubator.
The other couple said they underwent two separate egg retrievals and had two high-quality embryos that were destroyed in the toxic incubator.
Copyright © 2024, ABC Audio. All rights reserved.